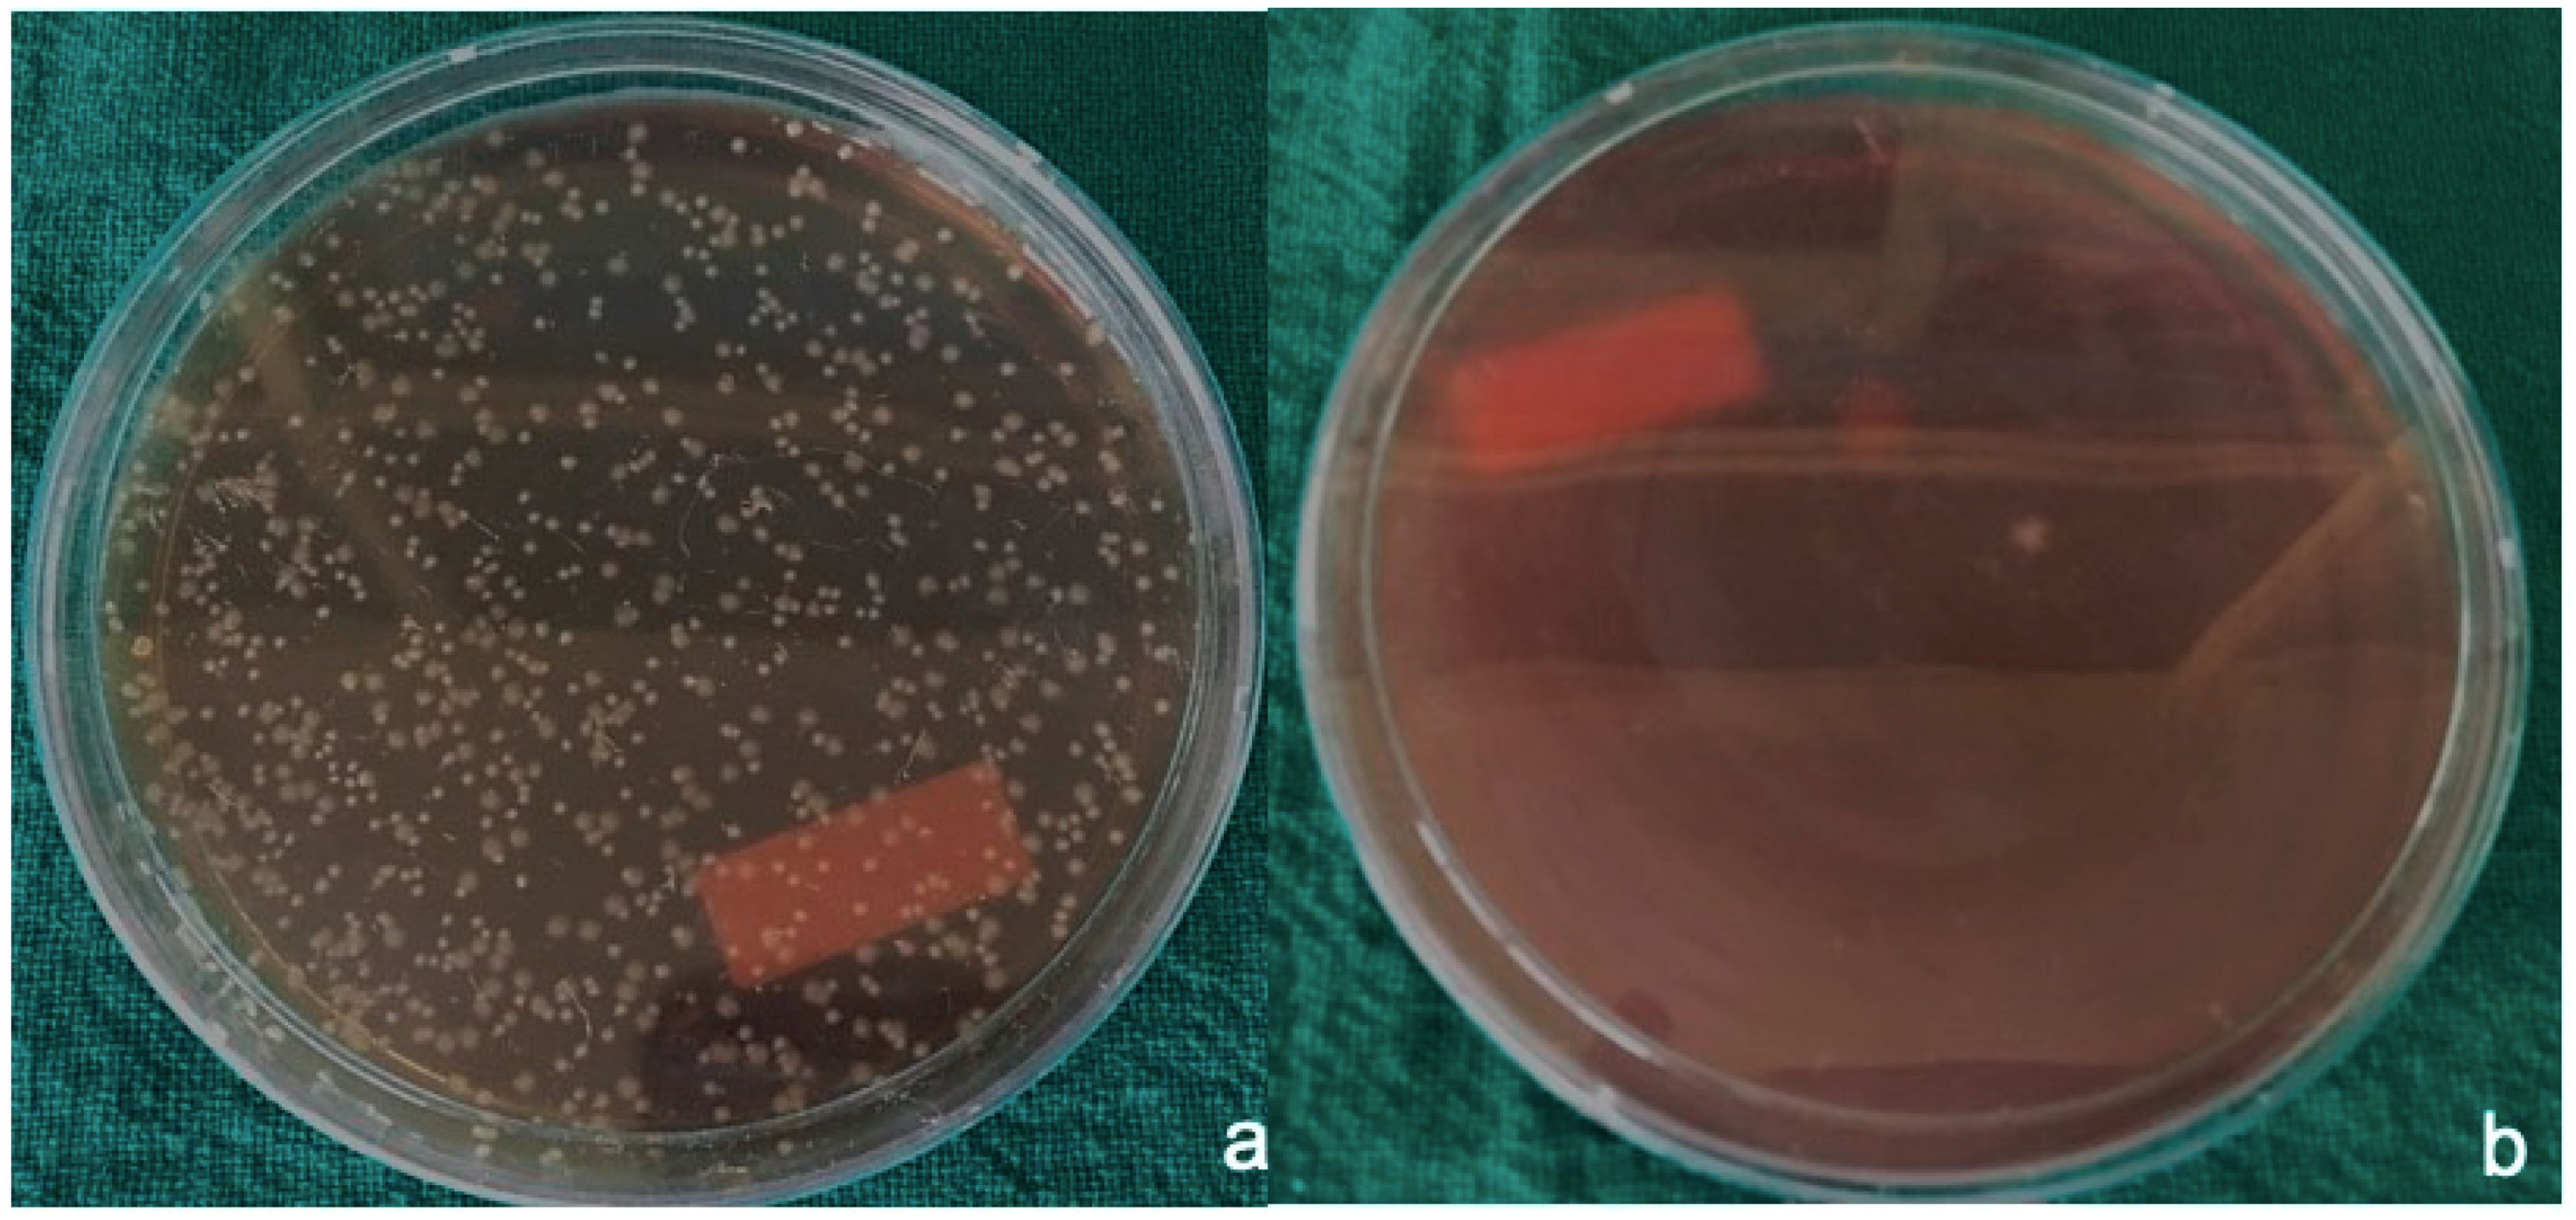
Materials 12 02848 g003 Materials 12 02848 g003
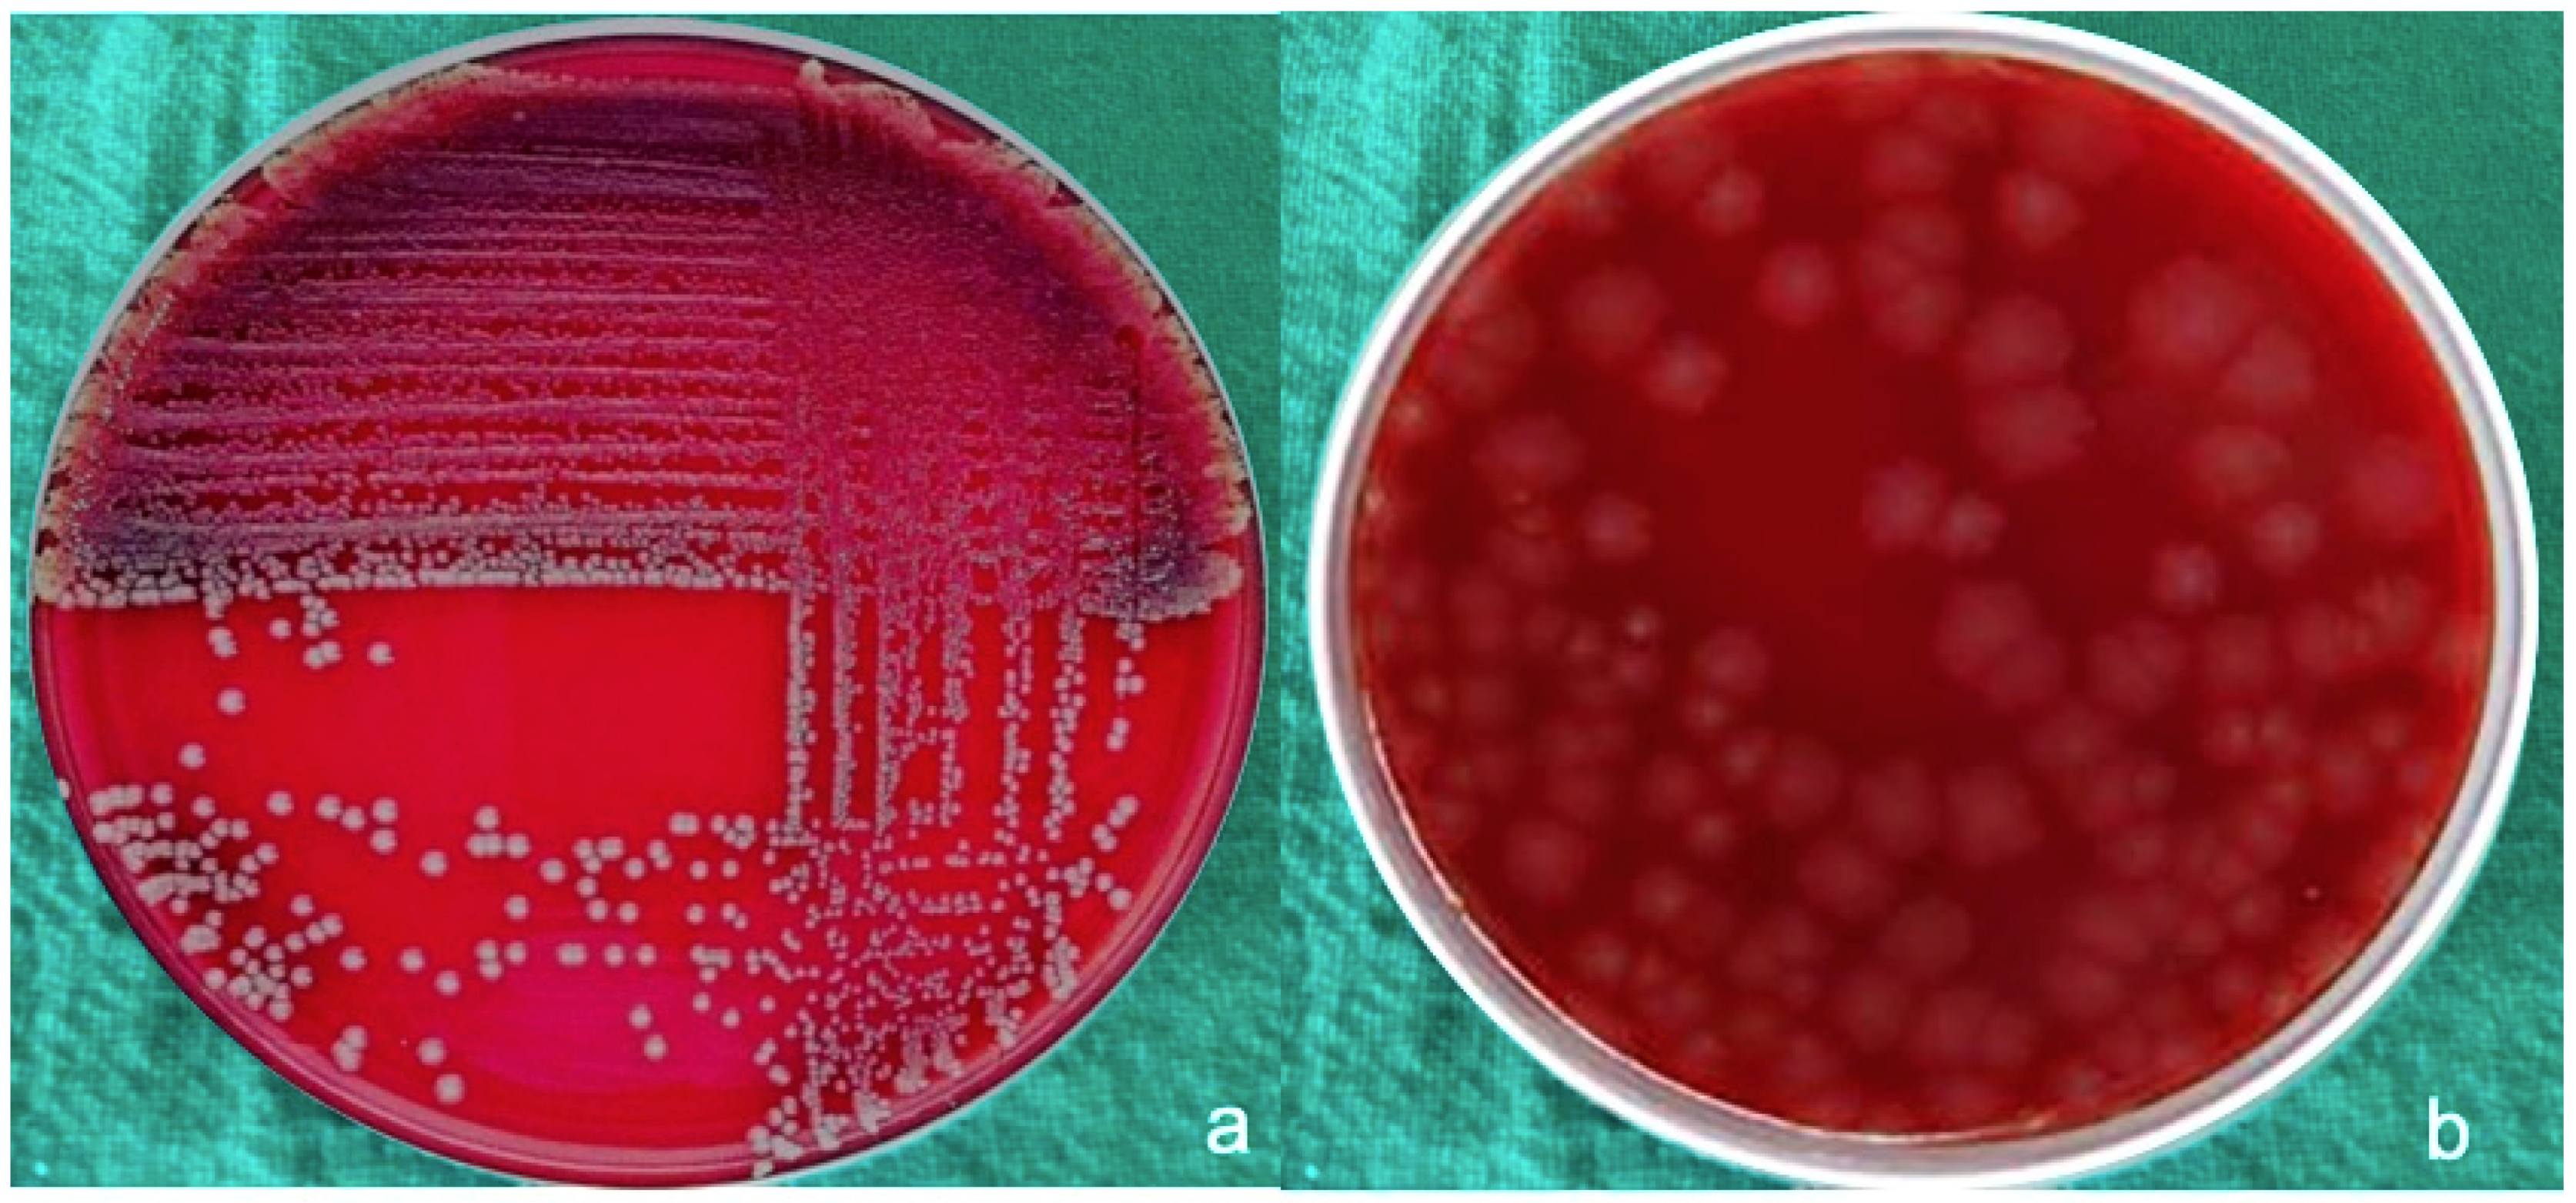
Materials 12 02848 g005 Materials 12 02848 g005
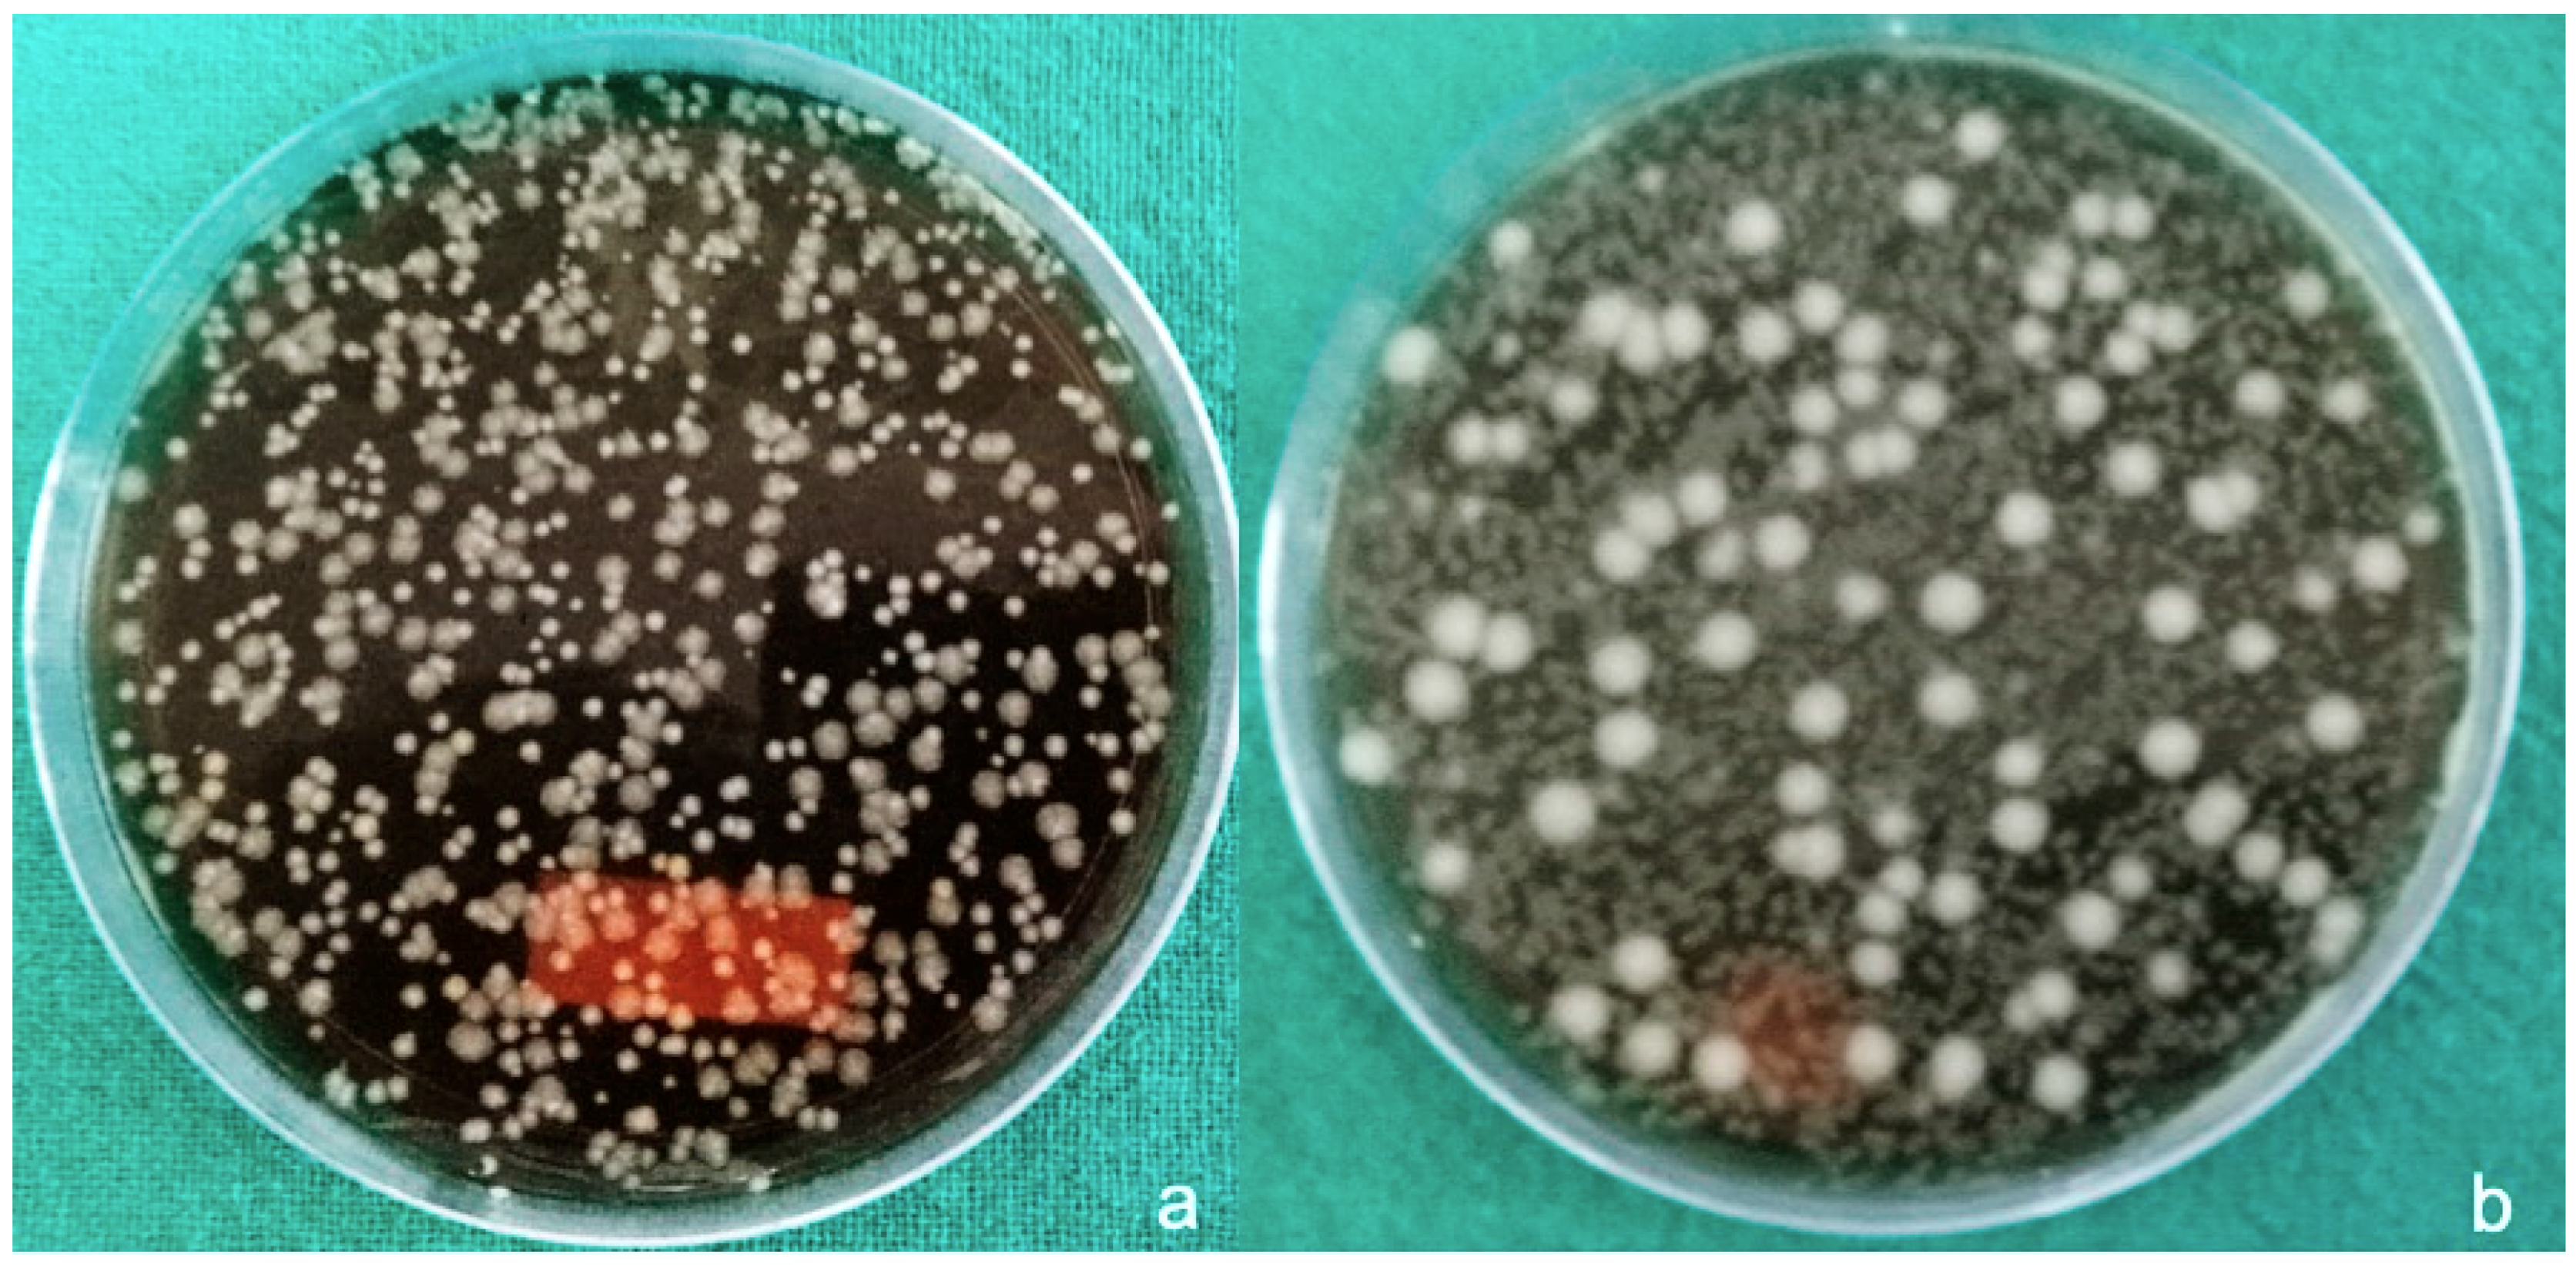
Materials 12 02848 g006 Materials 12 02848 g006

Bacterial Adherence Around Sutures of Different Material at Grafted Site: A Microbiological Analysis
Abstract
1. Introduction
2. Materials and Methods
- a)
- Silk suture: a nonabsorbable braided surgical suture obtained from cocoons of the silk worm and dyed black (Figure 1a).
- b)
- Vicryl: polyglactin suture which is coated and composed of a copolymer made from 90% glycolide and 10% L-LACTIDE (Figure 1b).
- c)
- Gut suture: strands of purified collagen taken from the serosal or submucosal layer of the small intestine of healthy ruminants (cattle, sheep, goats) or from beef tendon, which are twisted together. Catgut suture is a type of surgical suture that is naturally degraded by the body’s own proteolytic enzymes. Absorption is complete by 90 days, and full tensile strength remains for at least 7 days (Figure 1c).
- d)
- PTFE: synthetic fluoropolymer of tetrafluoroethylene. These are hydrophobic, non-wicking monofilament sutures which reduce friction to a great extent. This property prevents bacteria from adhering to the surface (Figure 1d).
- e)
- Polyamide suture material: a non-absorbable, monofilament suture whose fibers are tough, with high tensile strength, elasticity, and luster (Figure 1d).
2.1. Inclusion Criteria
- (a)
- Patients scheduled for implant or surgery with guided bone regeneration (GBR) with a surgical incision site large enough to include at least four sutures with a distance of 4 mm between them.
- (b)
- Patients willing to participate in the study, who filled in a signed consent form.
- (c)
- Patients without known systemic illness (diabetes, heart disease, immune deficiency, thrombocytopenia/coagulation enzymes deficiency).
- (d)
- Patients without the habit of chronic alcohol consumption/drug consumption or smoking.
- (e)
- No pregnancy.
2.2. Bacterial Culture
3. Results
4. Discussion
5. Conclusions
Author Contributions
Funding
Conflicts of Interest
References
- Ercan, U.K.; İbiş, F.; Dikyol, C.; Horzum, N.; Karaman, O.; Yıldırım, Ç.; Çukur, E.; Demirci, E.A. Prevention of bacterial colonization on non-thermal atmospheric plasma treated surgical sutures for control and prevention of surgical site infections. PLoS ONE 2018, 13, e0202703. [Google Scholar] [CrossRef] [PubMed]
- Henry-Stanley, M.J.; Hess, D.J.; Barnes, A.M.; Dunny, G.M.; Wells, C.L. Bacterial contamination of surgical suture resembles a biofilm. Surg. Infect. 2010, 11, 433–439. [Google Scholar] [CrossRef] [PubMed]
- Bucknall, T.E. The effect of local infection upon wound healing: An experimental study. Br. J. Surg. 1980, 67, 851–855. [Google Scholar] [CrossRef] [PubMed]
- Uff, C.R.; Scott, A.D.; Pockley, A.; Phillips, R.K. Influence of soluble suture factors on in vitro macrophage function. Biomaterials 1995, 16, 355–360. [Google Scholar] [CrossRef]
- Gristina, A.G.; Price, J.L.; Hobgood, C.D.; Webb, L.X.; Costerton, J.W. Bacterial colonization of percutaneous sutures. Surgery 1985, 98, 12–19. [Google Scholar] [PubMed]
- Hall-Stoodley, L.; Costerton, J.W.; Stoodley, P. Bacterial biofilms: From the natural environment to infectious diseases. Nat. Rev. Microbiol. 2004, 2, 95–108. [Google Scholar] [CrossRef]
- Fux, C.; Costerton, J.; Stewart, P.; Stoodley, P. Survival strategies of infectious biofilms. Trends Microbiol. 2005, 13, 34–40. [Google Scholar] [CrossRef]
- Chu, C.C.; Williams, D.F. Effects of physical configuration and chemical structure of suture materials on bacterial adhesion. A possible link to wound infection. Am. J. Surg. 1984, 147, 197–204. [Google Scholar] [CrossRef]
- Alexander, J.W.; Kaplan, J.Z.; Altemeier, W.A. Role of suture materials in the development of wound infection. Ann. Surg. 1967, 165, 192–199. [Google Scholar] [CrossRef]
- Katz, S.; Izhar, M.; Mirelman, D. Bacterial adherence to surgical sutures. A possible factor in suture induced infection. Ann. Surg. 1981, 194, 35–41. [Google Scholar] [CrossRef]
- Varma, S.; Ferguson, H.; Breen, H.; Lumb, W. Comparison of seven suture materials in infected wounds: An experimental study. J. Surg. Res. 1974, 17, 165–170. [Google Scholar] [CrossRef]
- Elek, S.D.; Cohen, P.E. The virulence of S. pyogenes for man: A study of the problems of wound infection. Br. J. Exp. Pathol. 1957, 38, 573–586. [Google Scholar] [PubMed]
- Raju, D.R.; Jindrak, K.; Weiner, M.; Enquist, I.F. A study of the critical bacterial inoculums to cause a stimulus to wound healing. Surg. Gynecol. Obstet. 1977, 144, 347–350. [Google Scholar] [PubMed]
- Kathju, S.; Nistico, L.; Hall-Stoodley, L.; Post, J.C.; Ehrlich, G.D.; Stoodley, P. Chronic surgical site infection due to suture-associated polymicrobial biofilm. Surg. Infect. 2009, 10, 457–461. [Google Scholar] [CrossRef] [PubMed]
- Kathju, S.; Lask, L.A.; Nistico, L.; Colella, J.J.; Stoodley, P. Cutaneous fistula from gastric remnant resulting from chronic suture-associated biofilm infection. Obes. Surg. 2010, 20, 251–256. [Google Scholar] [CrossRef] [PubMed]
- Karde, P.A.; Sethi, K.S.; Mahale, S.A.; Mamajiwala, A.S.; Kale, A.M.; Joshi, C.P. Comparative evaluation of two antibacterial-coated resorbable sutures versus noncoated resorbable sutures in periodontal flap surgery: A clinico-microbiological study. J. Indian Soc. Periodontol. 2019, 23, 220–225. [Google Scholar] [CrossRef] [PubMed]
- Asher, R.; Chacartchi, T.; Tandlich, M.; Shapira, L.; Polak, D. Microbial accumulation on different suture materials following oral surgery: A randomized controlled study. Clin. Oral Investig. 2019, 23, 559–565. [Google Scholar] [CrossRef] [PubMed]
- Pérez, S.S.; Ramírez, M.L.; Borgarello, M.Q.; Castellón, E.V.; Escoda, C.G. Antibacterial suture vs silk for the surgical removal of impacted lower third molars. A randomized clinical study. Med. Oral Patol. Oral Cir. Bucal 2016, 21, e95–e102. [Google Scholar] [CrossRef] [PubMed]
- Banche, G.; Roana, J.; Mandras, N.; Amasio, M.; Gallesio, C.; Allizond, V.; Angeretti, A.; Tullio, V.; Cuffini, A.M. Microbial Adherence on Various Intraoral Suture Materials in Patients Undergoing Dental Surgery. J. Oral Maxillofac. Surg. 2007, 65, 1503–1507. [Google Scholar] [CrossRef]
- Edmiston, C.E.; Seabrook, G.R.; Goheen, M.P.; Krepel, C.J.; Johnson, C.P.; Lewis, B.D.; Brown, K.R.; Towne, J.B. Bacterial Adherence to Surgical Sutures: Can Antibacterial-Coated Sutures Reduce the Risk of Microbial Contamination. J. Am. Coll. Surg. 2006, 203, 481–489. [Google Scholar] [CrossRef]
- Vicente, O.P.; Jimenez, L.L.; Sanchez-Garce’s, M.A.; Perez, S.S.; Escoda, C.G. A comparative study between two different suture materials in oral implantology. Clin. Oral Impl. Res. 2011, 22, 282–288. [Google Scholar] [CrossRef] [PubMed]

| Type of Suture Material | Aerobic Bacterial Growth (CFUs) | Anaerobic Bacterial Growth (CFUs) | p Value |
|---|---|---|---|
| Gut sutures | ≈30 × 104/suture | 10 × 104/suture | <0.05 |
| Silk sutures | ≈102 × 104/suture | 10 × 104/suture | |
| PTFE sutures | ≈300 × 104/suture | 20 × 104/suture | |
| Polyamide sutures | ≈300 × 104/suture | 20 × 104/suture | |
| Vicryl sutures | 444 × 104/suture | 50 × 104/suture | |
| p Value | <0.05 | ||
© 2019 by the authors. Licensee MDPI, Basel, Switzerland. This article is an open access article distributed under the terms and conditions of the Creative Commons Attribution (CC BY) license (http://creativecommons.org/licenses/by/4.0/).
Share and Cite
Mahesh, L.; Kumar, V.R.; Jain, A.; Shukla, S.; Aragoneses, J.M.; Martínez González, J.M.; Fernández-Domínguez, M.; Calvo-Guirado, J.L. Bacterial Adherence Around Sutures of Different Material at Grafted Site: A Microbiological Analysis. Materials 2019, 12, 2848. https://doi.org/10.3390/ma12182848
Mahesh L, Kumar VR, Jain A, Shukla S, Aragoneses JM, Martínez González JM, Fernández-Domínguez M, Calvo-Guirado JL. Bacterial Adherence Around Sutures of Different Material at Grafted Site: A Microbiological Analysis. Materials. 2019; 12(18):2848. https://doi.org/10.3390/ma12182848
Chicago/Turabian StyleMahesh, Lanka, Varun Raj Kumar, Anshi Jain, Sagrika Shukla, Juan Manuel Aragoneses, José María Martínez González, Manuel Fernández-Domínguez, and José Luis Calvo-Guirado. 2019. "Bacterial Adherence Around Sutures of Different Material at Grafted Site: A Microbiological Analysis" Materials 12, no. 18: 2848. https://doi.org/10.3390/ma12182848
APA StyleMahesh, L., Kumar, V. R., Jain, A., Shukla, S., Aragoneses, J. M., Martínez González, J. M., Fernández-Domínguez, M., & Calvo-Guirado, J. L. (2019). Bacterial Adherence Around Sutures of Different Material at Grafted Site: A Microbiological Analysis. Materials, 12(18), 2848. https://doi.org/10.3390/ma12182848

